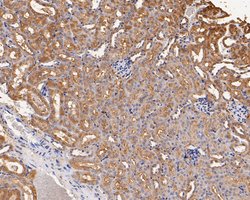
Invitrogen GABRB1 Polyclonal Antibody 100 &mu;L; Unconjugated:Antibodies,

missing translation for 'onlineSavingsMsg'
Learn More
Learn More
Description
Positive controls: Rat brain tissue lysates, 293T, LOVO, rat kidney tissue, human skin tissue, human breast tissue, human breast carcinoma tissue, human kidney tissue, mouse kidney tissue, mouse heart tissue, SH-SY5Y.
GABA, the major inhibitory neurotransmitter in the vertebrate brain, mediates neuronal inhibition by binding to the GABA/benzodiazepine receptor and opening an integral chloride channel.

Specifications
Specifications
| Antigen | GABRB1 |
| Applications | Flow Cytometry, Immunohistochemistry (Paraffin), Western Blot, Immunocytochemistry |
| Classification | Polyclonal |
| Concentration | 1 mg/mL |
| Conjugate | Unconjugated |
| Formulation | PBS with 50% glycerol, 0.2% BSA and 0.05% sodium azide; pH 7.4 |
| Gene | Gabrb1 |
| Gene Accession No. | P15431, P18505, P50571 |
| Gene Alias | AW061132; B230208N19Rik; GABA beta subunit; GABA(A) receptor; GABA(A) receptor subunit beta-1; GABA(A) receptor, beta 1; GABA(A)R beta-1; GABA-RB; Gabrb1; Gabrb-1; gamma-aminobutyric acid; gamma-aminobutyric acid (GABA) A receptor, beta 1; gamma-aminobutyric acid (GABA) A receptor, subunit beta 1; gamma-aminobutyric acid (GABA-A) receptor, subunit beta 1; gamma-aminobutyric acid A receptor beta 1; Gamma-aminobutyric acid receptor beta 1; gamma-aminobutyric acid receptor subunit beta-1; gamma-aminobutyric acid receptor, subunit beta 1; gamma-aminobutyric acid type A receptor beta1 subunit; gamma-aminobutyric acid type A receptor subunit beta1; GARB1; GBRB1; si:dkey-20i10.4 |
| Gene Symbols | Gabrb1 |
| Show More |
Product Title
By clicking Submit, you acknowledge that you may be contacted by Fisher Scientific in regards to the feedback you have provided in this form. We will not share your information for any other purposes. All contact information provided shall also be maintained in accordance with our Privacy Policy.
Spot an opportunity for improvement?